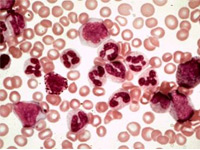

В прямом эфире радиостанции "Маяк" директор Центра Социальной Экономики Давид Мелик-Гусейнов ответил на вопросы ведущих и радиослушателей.

Россияне тратят на медицину больше, чем европейцы. К такому выводу пришли эксперты Всемирного банка.
Директор Центра Социальной Экономики Давид Мелик-Гусейнов в прямом эфире радиостанции Финам ФМ обсудил вопросы организации качественного
Как понять: должны ли в поликлинике сделать тот или иной анализ бесплатно: Или сколько дней ждать в очереди, если хочешь попасть на обследование или лечь в больницу по полису ОМС?
Центр Социальной Экономики принял участие в научно-практической работе на XVI Европейском Форуме Здравоохранения в Гастайне (Австрия).
Американо-Российский Деловой Совет (21-е Ежегодное Заседание) стартовало в г.Хьюстон США. В рамках конгресса, директор Центра Социальной Экономики
Центр Социальной Экономики совместно с компанией Эли Лилли провел серию круглых столов в городах России.
Впервые в Москве Центр Социальной Экономики провел, а также участвовал в конференции представителей пациентских ассоциаций и объединений.
Центр Социальной Экономики принял участие в Международном Форуме по лидерству в области диабета, который состоялся 15-16 ноября 2013 г., в городе Стамбуле, Турция.
Давид Мелик-Гусейнов, директор ЦСЭ принял участие в прямом эфире телеканала РБК. Тема программы с Марией Строевой
Самарский онкодиспансер провел образовательный семинар на тему современных методов лечения и организации медицинской помощи больным раком трахеи и легких.
Американские ученые утверждают, что победили проблему приспособляемости бактерий к антибиоткам. Правда это или пустое рекламное обещание?
На площадке Красноярского государственного медицинского университета встретились специалисты организаторы здравоохранения России и края.
17 декабря 2013 года в конференц-зале гостиницы «Даниловская» Даниловского монастыря Московской Епархии состоялась VI церемония награждения победителей
Оптимизация системы здравоохранения по оказанию кардиологической медицинской помощи населению имеет высокий социальный статус.
Центр Социальной Экономики провел рабочее совещание с организаторами здравоохранения Республики Удмуртия (г.Ижевск)
4 и 5 февраля в Москве врачи-онкологи, представители фармацевтических объединений, профильных органов власти, а также общественных и пациентских организаций
17–18 февраля в отеле Swissotel Красные холмы состоялась 9-я ежегодная международная конференция «Фармацевтический бизнес в России 2014: факторы роста»
В пресс центре РИА-новости прошел круглый стол и пресс-конференция, посвященная старту подготовки к дню МНО в России.
В Липецкой области дан старт проекту «Главная дорога». Его цель содействие в формировании эффективных подходов в области профилактики и лечения неинфекционных заболеваний.
В Омской области прошел круглый стол, посвященный борьбе и профилактике диабета. На мероприятие был приглашен директор Центра Социальной Экономики Давид Мелик-Гусейнов.
Директор Центра Социальной Экономики Давид Мелик-Гусейнов принял участие во всемирном форуме специалистов, борющихся с проблемой недержания мочи у детей и взрослых.
За последние пять лет число больных диабетом во Владимирской области увеличилось на 6 тысяч человек и составляет сейчас более 41 тысячи больных.
Общероссийский союз общественных объединений «Ассоциация онкологов России» и Некоммерческое партнерство «Равное право на жизнь» организовали всероссийскую
"Главную дорогу в онкологии" обсуждали в Санкт-Петербурге главный онколог Минздрава РФ, директор РОНЦ имени Н.Н.Блохина Михаил Давыдов,
26 апреля 2016 года прошло заседание Стратегического консилиума в городе Волгоград.
29 марта 2016 года состоялся Стратегический консилиум
 Центр Социальной Экономики принял участие в научно-практической работе на XVI Европейском Форуме Здравоохранения в Гастайне (Австрия).
Центр Социальной Экономики принял участие в научно-практической работе на XVI Европейском Форуме Здравоохранения в Гастайне (Австрия).
В Пензе состоялось очередное мероприятие проекта «Главная дорога», содействующего разработке стратегических «дорожных карт» развития регионального здравоохранения.
ФАС РФ сообщает, что большинство продающихся в России лекарств дороже, чем аналогичные препараты за рубежом.
Центр Социальной Экономики приглашен к участию в пресс-брифинге, организованного компанией Астра Зенека, по вопросам формирования мультиканальной системы коммуникации фармацевтической индустрии и медицинского сообщества.
Аналитики исследовательского центра информационного агентства Итар-Тасс совместно с Центром Социальной Экономики
С 11 по 13 марта 2014 года в Международном мультимедийном пресс-центре (ММПЦ) РИА Новости прошло крупнейшее мероприятие России
10 февраля 2014 года состоялось заседание Экспертного совета по развитию конкуренции в социальной сфере и здравоохранении при Федеральной антимонопольной службе
Центр Социальной Экономики совместно с департаментом здравоохранения Тульской области, организаторами мед и фарм помощи региона, НП «Равное Право на жизнь»
В декабре 2013 года состоялся визит представителей российского здравоохранения в город Нью-Йорк для обсуждения с мировым профессиональным сообществом
По приглашению администрации Астраханской области директор Центра Социальной Экономики Давид Мелик-Гусейнов принял участие в торжественных мероприятиях,
Маги и экстрасенсы, оказывающие паранормальные медицинские услуги должны быть вне закона и запрещены.
Центр Социальной Экономики провел установочное мероприятие – круглый стол по организации процессов в области профилактики и лечения онкологических заболеваний
Меморандум о стратегическом сотрудничестве, партнерстве и взаимопонимании будет подписан между Национальным институтом
В Казани завершилась третья сессия Международного форума «Европа и Россия: Вектор развития. Гармонизация»
В рамках международного форума «Оценка технологий здравоохранения как эффективный инструмент принятия управленческих решений»
7 сентября во Владивостоке директор «Центра Социальной Экономики» к.ф.н. Давид Мелик-Гусейнов принял участие в заседании экспертов и представителей органов управления здравоохранением
 16 июля в редакции газеты «Аргументы и факты» прошел круглый стол на тему: «Перспективы развития фармацевтического рынка: интенсивный рост или стагнация?»
16 июля в редакции газеты «Аргументы и факты» прошел круглый стол на тему: «Перспективы развития фармацевтического рынка: интенсивный рост или стагнация?»
Центр Социальной Экономики подготовил аналитические материалы о возможных вариантах реализации офсетных сделок (risk) на территории Российской Федерации в рамках
При поддержке наших партнеров – МГУ им. М.В. Ломоносова и компании Астра Зенека была организована программа пребывания нобелевского лауреата 2003 года Питера Агре в России.
Страница 3 из 4